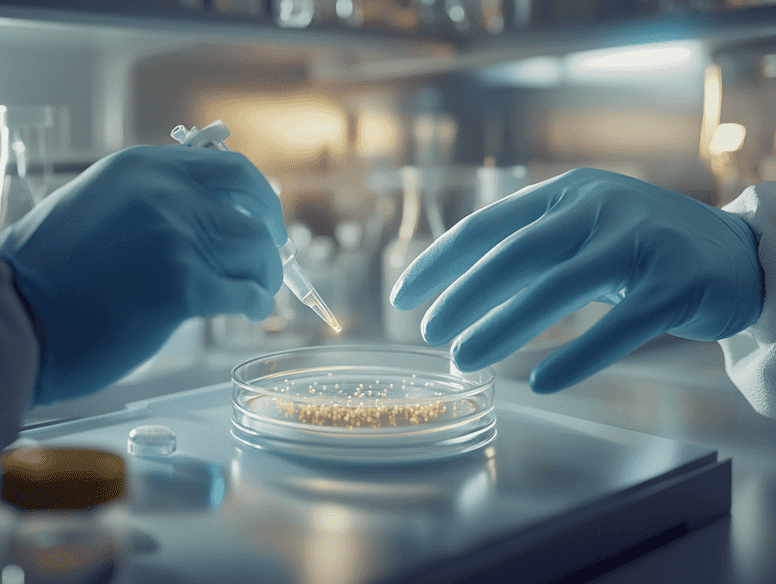
A stock market graph showing upward trends, symbolizing potential growth

Why Cabaletta Bio Could Be the Underdog Investors Are Overlooking

Is Cabaletta Bio the Next Big Biotech Opportunity?
Cabaletta Bio has been making waves in the biotech sector, but not always for the reasons investors hope. While the company has faced challenges, there’s a growing sense that it could be a hidden gem for those willing to take a calculated risk. Could this underdog be the next big thing in biotech? Let’s dive into the details.
What Makes Cabaletta Bio Stand Out?
Cabaletta Bio specializes in developing targeted cell therapies for autoimmune diseases. Unlike many biotech companies that focus on broad-spectrum treatments, Cabaletta is carving out a niche in a highly specific and potentially lucrative market.
Here’s what sets them apart:
- Innovative Technology: Their proprietary CART-T technology is designed to selectively target and eliminate disease-causing B cells, offering a more precise treatment option.
- Focused Pipeline: With a clear focus on autoimmune diseases, Cabaletta is addressing unmet medical needs that could lead to significant market opportunities.
- Experienced Leadership: The company’s leadership team brings decades of experience in biotech and pharmaceuticals, which could be a key factor in navigating the challenges ahead.

The Challenges Facing Cabaletta Bio
Despite its potential, Cabaletta Bio is not without its hurdles. The company has faced setbacks in clinical trials, leading to skepticism among investors. However, these challenges are not uncommon in the biotech industry, where high risk often comes with the potential for high reward.
Key challenges include:
- Clinical Trial Risks: Like any biotech firm, Cabaletta’s success hinges on the outcomes of its clinical trials. Any delays or failures could significantly impact its stock price.
- Funding Concerns: Developing cutting-edge therapies is expensive, and Cabaletta may need to secure additional funding to continue its operations.
- Market Competition: The biotech space is crowded, with numerous companies vying for dominance in similar therapeutic areas.
Why Some Investors Are Still Optimistic
Despite the challenges, there are reasons to remain optimistic about Cabaletta Bio’s future. For one, the company’s focus on autoimmune diseases positions it in a market with significant unmet needs. Additionally, recent updates suggest that Cabaletta is making progress in its clinical trials, which could be a turning point.
Here’s why some investors are holding on:
- Market Potential: The global autoimmune disease market is projected to grow significantly in the coming years, providing a lucrative opportunity for successful therapies.
- Positive Early Data: Preliminary results from Cabaletta’s trials have shown promise, boosting confidence in its technology.
- Strategic Partnerships: Collaborations with other biotech firms and research institutions could provide the resources and expertise needed to overcome challenges.
Should You Consider Investing in Cabaletta Bio?
Investing in biotech stocks like Cabaletta Bio is not for the faint of heart. The sector is known for its volatility, and individual companies can experience dramatic swings in value based on clinical trial results, regulatory decisions, and market sentiment. However, for those willing to take a calculated risk, Cabaletta Bio could offer significant upside potential.
Factors to consider before investing:
- Risk Tolerance: Are you comfortable with the high-risk, high-reward nature of biotech investing?
- Long-Term Outlook: Cabaletta’s success will likely take years to materialize. Are you prepared to hold your investment for the long term?
- Diversification: Is Cabaletta Bio a good fit within your broader investment portfolio?
The Road Ahead for Cabaletta Bio
Looking ahead, Cabaletta Bio’s future will largely depend on its ability to navigate the challenges of clinical trials and secure the funding needed to bring its therapies to market. While the road may be rocky, the potential rewards could be substantial for those who believe in the company’s vision.
Could Cabaletta Bio be the next big success story in biotech? Only time will tell, but one thing is certain: this is a company worth watching.

Final Thoughts: Is Now the Time to Act?
Cabaletta Bio represents both a challenge and an opportunity for investors. While the risks are undeniable, the company’s innovative approach and focus on a growing market make it a compelling option for those with a high tolerance for risk. If you’re looking for a potential underdog story in the biotech sector, Cabaletta Bio might just be worth a closer look.
Read on...
Table Of Contents
Legal Stuff

